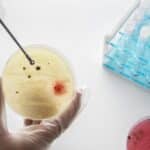
Test Rapido Dell’Ureasi Per HP
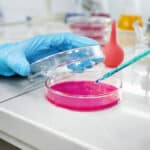
Esame Stress Ossidativo

Promozione Senologica
⚠️ Promozione Senologica! ⚠️ La Radiologica Romana propone: PACCHETTO SENOLOGIA – Mammografia con Tomosintesi – Ecografia Mammaria – Visita Senologica Da €180,00 a €162,00 Approfitta ora della nostra

⚠️ Promozione Senologica! ⚠️ La Radiologica Romana propone: PACCHETTO SENOLOGIA – Mammografia con Tomosintesi – Ecografia Mammaria – Visita Senologica Da €180,00 a €162,00 Approfitta ora della nostra

⚠️ Promozione Senologica! ⚠️ La Radiologica Romana propone: PACCHETTO SENOLOGIA – Mammografia con Tomosintesi – Ecografia Mammaria – Visita Senologica Da €180,00 a €162,00 Approfitta ora della nostra

⚠️ Promozione Senologica! ⚠️ La Radiologica Romana propone: PACCHETTO SENOLOGIA – Mammografia con Tomosintesi – Ecografia Mammaria – Visita Senologica Da €180,00 a €162,00 Approfitta ora della nostra

⚠️ Promozione Senologica! ⚠️ La Radiologica Romana propone: PACCHETTO SENOLOGIA – Mammografia con Tomosintesi – Ecografia Mammaria – Visita Senologica Da €180,00 a €162,00 Approfitta ora della nostra

Il Laboratorio Analisi Cliniche si occupa di analizzare campioni biologici di sangue, secrezioni corporee e tessuti.
I campioni prelevati dai pazienti vengono analizzati da personale altamente specializzato, per valutare i possibili fattori che possono essere causa di patologie o problemi di salute. Per esaminare le analisi cliniche nel nostro Laboratorio Analisi utilizziamo solo apparecchiature automatiche di ultima generazione e abbiamo adottato un Sistema di Gestione della Qualità conforme alla norma UNI EN ISO 9001:2008.
Utilizza la chat del sito per parlare con un nostro operatore.
Prenota ora!
Tel: 0687165363
Da oggi puoi prenotare online in modo facile, con un click
Compila il form sottostante per essere ricontattato

OMEGA SCREENING L’Omega screening è il punto di partenza per ritrovare salute e benessere. La corretta valutazione del rapporto tra acidi grassi omega-6 e acidi

Test Health and Wellness e Intolerance il pannello “Salute ossa” il pannello ” Risposta infiammatoria” il pacchetto completo “Health & Wellness Complete” (che comprende tutti i

Il Test 108 Alimenti è il Test che aiuta a scoprire eventuali intolleranze alimentari: misura gli anticorpi IgG totali prodotti dal sistema immunitario contro uno o più alimenti specifici tra i 108 testati

Il test sierologico semi-quantitativo è utile per analizzare la risposta dell’organismo a seguito del vaccino per Sars-Cov-19. Il test potrà essere richiesto da coloro che

Il test sierologico misura gli anticorpi anti-SARS-CoV-2 che il nostro organismo produce se entra in contatto con il Covid-19. Si misurano due diversi anticorpi, le immunoglobuline, IgM e

IL TEST ONCONEXT RISK OncoNext Risk è un test diagnostico che permette di eseguire un’analisi genetica multipla per valutare la predisposizione a vari tipi di

Presso il centro Radiologica Romana è attualmente disponibile il test molecolare per l’infezione da COVID-19. Il tampone molecolare rimane lo standard d’elezione per la diagnosi

Tampone Rapido Covid-19 di Terza Generazione Il Centro Radiologica Romana è dotato di strumentazioni di ultima generazione per effettuare i Tamponi Rapidi o “ Test

Test BRCA e Diagnosi predispozione dello sviluppo Tumore Ovaio/Utero La possibilità di individuare i soggetti a rischio di sviluppare una neoplasia rappresenta oggi il miglior

Presso la Radiologica Romana è possibile eseguire il “test rapido” per il Coronavirus SARS COV-2, che può essere effettuato su APPUNTAMENTO. Il Test rapido IgG/IgM

COS’È IL TEST HELICOBACTER Il Test consiste nell’esaminare un frammento di mucosa (biopsia) prelevato durante la gastroscopia. La biopsia viene posta in un liquido giallo

ESAME ISTOLOGICO Si tratta di un esame microscopico che viene effettuato su un frammento di tessuto e le sue cellule, per confermare o escludere la

DERMATOFITI Questa tipologia di esame di laboratorio permette di diagnosticare un’infezione su unghie di mani e piedi causata da diverse tipologie di agenti patogeni, come

La presenza di un tumore nell’organismo può essere rivelata attraverso il dosaggio di particolari sostanze presenti nel sangue; I markers tumorali sono, appunto, analisi del sangue

MALATTIE AUTOIMMUNI La malattia autoimmune è una patologia determinata da un’alterazione del sistema immunitario che riconosce come estranee le cellule dell’organismo e le attacca. Questa

È un esame specifico che permette di diagnosticare l’intolleranza ad alcuni alimenti. COSA SONO LE INTOLLERANZE ALIMENTARI Sono una reazione avversa agli alimenti e possono

Il Gastropanel è un test indolore e non invasivo che valuta lo stato di salute dello stomaco. COME FUNZIONA E A COSA SERVE IL GASTROPANEL

L’ormone antimulleriano (AMH) indica la cosiddetta riserva ovarica, ossia il numero di follicoli che la donna ha a disposizione. Misurando la quantità circolante di questo ormone

Le analisi consigliate per valutare il grado di stress ossidativo e le potenzialità antiossidanti dell’organismo sono il D-Roms e il dosaggio delle vitamine ad azione

L’esame tossicologico urine è un test antidroga rapido e indolore. Attraverso l’analisi delle urine è possibile rilevare tracce di droghe e di farmaci con obbligo

Test Alex 2 Il Test Alex 2 è il test di allergologia molecolare di ultima generazione , finalizzato all’identificazione e al dosaggio delle immunoglobuline IgE totali

Il Prenatal SAFE è un esame genetico non invasivo che rileva alterazioni cromosomiche strutturali del feto e aneuploidie attraverso l’analisi del DNA fetale, isolato da un

Il Nostro Centro offre la possibilità di usufruire di due pacchetti Cardiologici.

Scopri tutti i servizi del Laboratorio Analisi presenti in Radiologica Romana e trova l’esame più adatto alle tue esigenze.
La medicina di laboratorio si occupa dei servizi diagnostici generali e specialistici su campioni biologici e produce un referto sullo stato di salute del paziente. Le analisi del sangue servono ad escludere, diagnosticare, determinare e valutare il progresso delle patologie.
Analizza campioni biologici di sangue, o di altri liquidi, secrezioni corporee o tessuti provenienti dai pazienti.
Il nostro Laboratorio Analisi è suddiviso in diversi settori:
Il campione biologico viene analizzato in apparecchiature automatiche con lo scopo di valutarne la composizione e i fattori indicanti problemi o patologie.
Gli analizzatori automatici vengono caricati con provette contenenti il campione, da cui prelevano un’aliquota usata per il processo d’analisi.
Il protocollo prevede una fase d’ incubazione del campione al quale si aggiungono uno o più reagenti all’interno delle cuvette di reazione, per ottenere infine la misura vera e propria e la conversione del risultato in unità di misura specifiche.
I risultati delle analisi cliniche devono essere sempre sottoposti al vaglio di personale specializzato che valida e firma il referto finale. E’ sempre importante di avere più parametri per produrre un quadro clinico: elementi essenziali, per esempio, sono l’età, il sesso e il precedente stato di salute del paziente. In alcuni casi, i risultati ottenuti possono richiedere ulteriori screening diagnostici per identificare una patologia o altri test di controllo prima di sottoporsi ad eventuali interventi chirurgici.
Compila il modulo con il tuo nome e il numero su cui possiamo chiamarti, ed un nostro operatore ti ricontatterà entro 5 minuti.
Il servizio è attivo:
Lun-Sab --> 08.00-20.00
©2020. Radiologica Romana s.r.l.


Il nostro centralino è a tua disposizione, chiama il numero 06 30890077
Prenota online con un clic, in maniera facile e veloce
Scrivici su whatsapp per prenotare una visita al numero 3283375530
Clicca l'icona blu in basso a destra per iniziare la conversazione con un nostro operatore

Diagnostica per Immagini